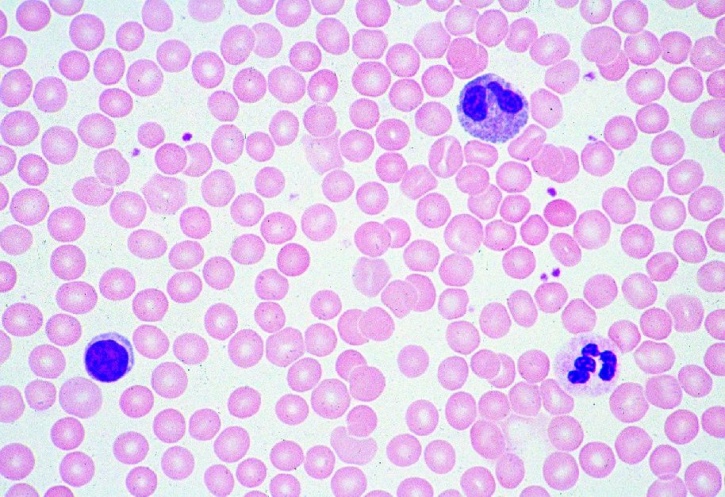
Mikropräparat - Blut vom Menschen, Ausstrich, Rote und weiße Blutkörperchen, Färbung nach Giemsa

in Schachteln zu 100 Stück.
Empfohlenes Zubehör
Objektträger, 50 Stück, halbweiß
Objektträger, 50 Stück, halbweiß, geschnitten, ca. 1 bis...
2,34 €
inkl. 19 % USt zzgl. Versandkosten
Zuletzt angesehen
Ersatzteil zum Experimentierkoffer 31756gam, Magnet und Kompass 20 Ösen für...
2,51 €
inkl. 19 % USt zzgl. Versandkosten
SOMA-Würfel, 2x2x2 cm, 150 farbige Würfel aus RE-WOOD®
SOMA-Würfel, 150 farbige Würfel
31,40 €
inkl. 19 % USt zzgl. Versandkosten
Schüler-Bruchsatz - lineare Strecken - Darstellung mit Grundplatte
51teiliger Satz auf stabilem ca. 4 mm starken Kunststoff, Format 24 x 2,4 cm
13,55 €
inkl. 19 % USt zzgl. Versandkosten
Kunden kauften auch
Mikropräparat - Bakterientypen: Kokken, Bazillen, Spirillen
Mikropräparat - Bakterientypen: Kokken, Bazillen, Spirillen
12,50 €
inkl. 19 % USt zzgl. Versandkosten
Mikropräparat - Dünndarm (lleum), des Menschen, quer
Mikropräparat - Dünndarm (lleum), des Menschen, quer
12,50 €
inkl. 19 % USt zzgl. Versandkosten
Mikropräparat - Skelettmuskulatur, längs. Querstreifung
Mikropräparat - Skelettmuskulatur, längs. Querstreifung, Myofibrillen, Kerne
10,95 €
inkl. 19 % USt zzgl. Versandkosten
Mikropräparat - Blatt vom Flieder (Syringa), quer, Typisches dikotyles bifaziales Blatt
Einzelpräparat aus Serie Blütenpflanzen V, Das Blatt, Botanik
10,59 €
inkl. 19 % USt zzgl. Versandkosten
Mikropräparat - Bacillus cereus, Bodenbakterien. Ausstrich von Kultur
Einzelpräparat - Stäbchenförmige Bakterien, sporenbildend
10,95 €
inkl. 19 % USt zzgl. Versandkosten
Blende mit 3 Einzelspalten und 1 Doppelspalt
für Experimente zur optischen Beugung und Interferenz
18,08 €
inkl. 19 % USt zzgl. Versandkosten
Mikropräparat - Physcia, Laubflechte, Thallus mit symbiotischen Algen, quer
Einzelpräparat, Lichenes - Flechten
10,95 €
inkl. 19 % USt zzgl. Versandkosten
Mikropräparat - Haut des Menschen quer, (vertikal)
Mikropräparat - Haut des Menschen quer, (vertikal). Schweißdrüsen, verhorntes,...
10,95 €
inkl. 19 % USt zzgl. Versandkosten
Experimentiersatz, Reizleitung an Nervenfasern
Reizleitung an Nervenfasern: Nerven wie Drahtseile (Prof. Dr. Matthias Ducci /...
191,26 €
inkl. 19 % USt zzgl. Versandkosten
Mikropräparat - Leber vom Salamander, quer, Einfache Tierzellen
Mikropräparat - Leber vom Salamander, quer, Einfache Tierzellen
10,95 €
inkl. 19 % USt zzgl. Versandkosten
Becherglas, Borosilikatglas, hF, 250 ml
Becherglas, Borosilikatglas, HF, 250 ml
3,28 €
inkl. 19 % USt zzgl. Versandkosten
Objektträger, 50 Stück, halbweiß
Objektträger, 50 Stück, halbweiß, geschnitten, ca. 1 bis...
2,34 €
inkl. 19 % USt zzgl. Versandkosten
Mikropräparat - Bakterientypen: Drei Ausstriche in einem Präparat mit Kokken, Bazillen und Spirillen
Einzelpräparat, Bakterientypen
12,50 €
inkl. 19 % USt zzgl. Versandkosten
Spritzflasche, Polyethylen, mit Spritzverschluss, Inhalt 500 ml
Spritzflasche, Polyethylen, mit Spritzverschluss, Inhalt 500 ml
6,10 €
inkl. 19 % USt zzgl. Versandkosten
Präparatekasten für 12 Präparate. Standardausführung
Mikroskopie, Zubehör
18,80 €
inkl. 19 % USt zzgl. Versandkosten
Mikropräparat - Mischpräparat: verschiedene typische Bakterienreinkulturen
Einzelpräparat, Bakterientypen
12,50 €
inkl. 19 % USt zzgl. Versandkosten
Schülermikroskop mit LED-Beleuchtung
stabiles Basismikroskop für den Unterricht mit hochwertiger Optik,...
210,28 €
inkl. 19 % USt zzgl. Versandkosten
Ergänzungsbedarf zur Bakteriologie: Impfösen, 2 Stück
Ergänzungsbedarf zur Bakteriologie: Impfösen, 2 Stück
23,80 €
inkl. 19 % USt zzgl. Versandkosten
Mikropräparat - Röhrenknochen, quer und längs
Mikropräparat - Röhrenknochen, quer und längs, kompakte Substanz. Färbung der...
12,50 €
inkl. 19 % USt zzgl. Versandkosten
Mikropräparat - Blut vom Menschen, Ausstrich, Rote und weiße Blutkörperchen, Färbung nach Giemsa
Mikropräparat - Blut vom Menschen, Ausstrich, Rote und weiße Blutkörperchen,...
10,59 €
inkl. 19 % USt zzgl. Versandkosten
Mikropräparat - Diatomeen, Kieselalgen. Streupräparat mit vielen Arten
Einzelpräparat aus Serie, Lebensraum Meerwasser, Ökologie und Umweltschutz
10,59 €
inkl. 19 % USt zzgl. Versandkosten
Verifizierter Kauf *
Geschrieben von verifizierten Kunden am 20.12.2015
Tolle Ausführung
Eigentlich das beste bisher
Herstellerkennzeichnung
Herstellerkennzeichnung
Name: Cornelsen Experimenta GmbHE-Mail Adresse: info@cornelsen-experimenta.de
Land: DE